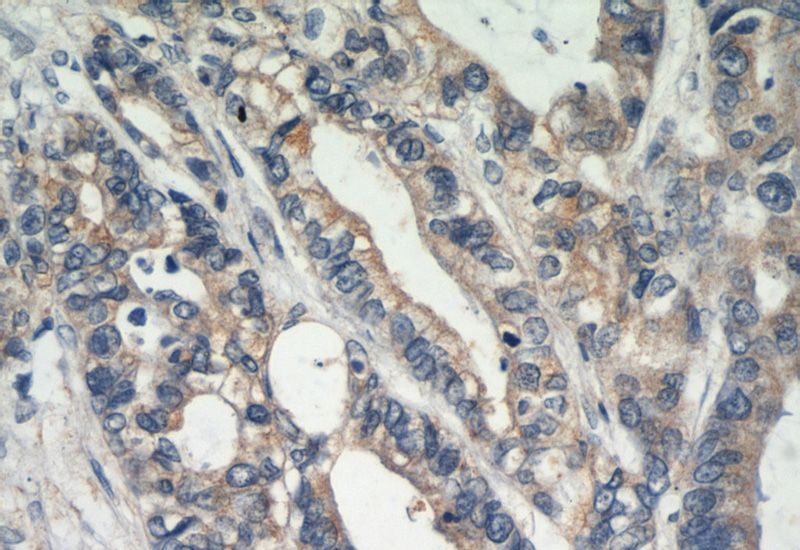
Immunohistochemical of paraffin-embedded human colon cancer using Catalog No:110289(CDH1-Specific antibody) at dilution of 1:50 (under 40x lens)

-
Product Name
E-cadherin antibody
- Documents
-
Description
E-cadherin Rabbit Polyclonal antibody. Positive FC detected in HepG2 cells. Positive IF detected in HepG2 cells. Positive IHC detected in human colon cancer tissue, human liver cancer tissue. Positive WB detected in PC-3 cells. Observed molecular weight by Western-blot: 97 kDa,124 kDa
-
Tested applications
ELISA, WB, IF, IHC, FC
-
Species reactivity
Human,Mouse,Rat; other species not tested.
-
Alternative names
Arc 1 antibody; Cadherin 1 antibody; CAM 120/80 antibody; CD324 antibody; CDH1 antibody; CDHE antibody; E cadherin antibody; ECAD antibody; E-cadherin antibody; Epithelial cadherin antibody; LCAM antibody; UVO antibody; Uvomorulin antibody
-
Isotype
Rabbit IgG
-
Preparation
This antibody was obtained by immunization of Peptide (Accession Number: NM_004360). Purification method: Antigen affinity purified.
-
Clonality
Polyclonal
-
Formulation
PBS with 0.02% sodium azide and 50% glycerol pH 7.3.
-
Storage instructions
Store at -20℃. DO NOT ALIQUOT
-
Applications
Recommended Dilution:
WB: 1:200-1:2000
IHC: 1:20-1:200
IF: 1:10-1:100
-
Validations

Immunofluorescent analysis of HepG2 cells, using CDH1 antibody Catalog No:110289 at 1:25 dilution and Rhodamine-labeled goat anti-rabbit IgG (red). Blue pseudocolor = DAPI (fluorescent DNA dye).
Immunohistochemical of paraffin-embedded human colon cancer using Catalog No:110289(CDH1-Specific antibody) at dilution of 1:50 (under 40x lens)

1X10^6 HepG2 cells were stained with 0.2ug CDH1-Specific antibody (Catalog No:110289, red) and control antibody (blue). Fixed with 4% PFA blocked with 3% BSA (30 min). Alexa Fluor 488-congugated AffiniPure Goat Anti-Rabbit IgG(H+L) with dilution 1:200.

PC-3 cells were subjected to SDS PAGE followed by western blot with Catalog No:110289(CDH1-Specific antibody) at dilution of 1:500
-
Background
E-cadherin (epithelial cadherin), also known as CDH1 (cadherin 1) or CAM 120/80, is a classical member of the cadherin superfamily which also include N-, P-, R-, and B-cadherins. It has been regarded as a marker for spermatogonial stem cells in mice(PMID:23509752). E-cadherin is expressed on the cell surface in most epithelial tissues. The extracellular region of E-cadherin establishes calcium-dependent homophilic trans binding, providing specific interaction with adjacent cells, while the cytoplasmic domain is connected to the actin cytoskeleton through the interaction with p120-, α-, β-, and γ-catenin (plakoglobin). E-cadherin is important in the maintenance of the epithelial integrity, and is involved in mechanisms regulating proliferation, differentiation, and survival of epithelial cell. E-cadherin may also play a role in tumorigenesis. It is considered to be an invasion suppressor protein and its loss is an indicator of high tumor aggressiveness. This antibody is specific to CDH1.
-
References
- Pan X, Wang P, Luo J. Adipogenic changes of hepatocytes in a high-fat diet-induced fatty liver mice model and non-alcoholic fatty liver disease patients. Endocrine. 48(3):834-47. 2015.
- Hu TH, Yao Y, Yu S. SDF-1/CXCR4 promotes epithelial-mesenchymal transition and progression of colorectal cancer by activation of the Wnt/β-catenin signaling pathway. Cancer letters. 354(2):417-26. 2014.
- Liu T, Nie F, Yang X. MicroRNA-590 is an EMT-suppressive microRNA involved in the TGFβ signaling pathway. Molecular medicine reports. 12(5):7403-11. 2015.
Related Products / Services
Please note: All products are "FOR RESEARCH USE ONLY AND ARE NOT INTENDED FOR DIAGNOSTIC OR THERAPEUTIC USE"
